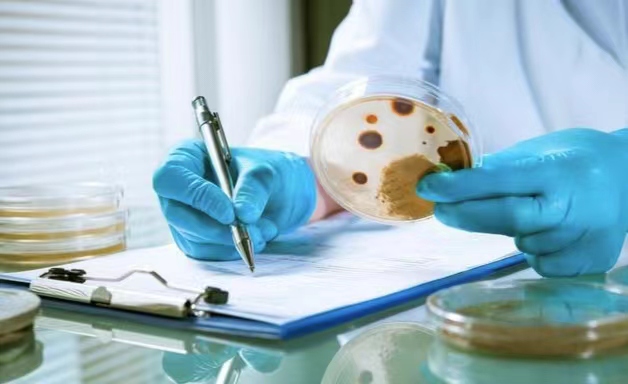
掌握调味品检测报告有效期,确保食品安全 掌握调味品检测报告有效期,确保食品安全

新闻动态
调味品检测报告有效期多久
调味品作为食品加工的重要原料,其质量安全直接关系到最终产品的安全性。因此,定期检测调味品的各项指标,并及时掌握检测报告,对于保障食品安全至关重要。调味品检测报告可以反映出产品的卫生状况、理化特性、添加剂含量等信息,为企业提供依据,指导后续生产和管理。
调味品检测报告的有效期通常由检测机构根据检测方法、样品性质等因素综合确定。一般来说,微生物指标的有效期较短,通常为3-6个月;理化指标的有效期相对较长,可达1年左右。同时,不同种类的调味品,其检测报告有效期也存在差异。例如,酱油的有效期可能为6个月,而白糖的有效期则可达1年。
影响调味品检测报告有效期的主要因素包括:1.检测方法:采用快速检测方法的报告有效期较短,而采用标准化方法的报告有效期较长。2.样品状态:新鲜样品的报告有效期较长,而贮存时间较长的样品报告有效期较短。3.检测指标:微生物指标的有效期较短,理化指标的有效期较长。4.产品特性:高水分、易变质的调味品报告有效期较短,低水分、稳定性较好的报告有效期较长。
为延长调味品检测报告的有效期,可采取以下措施:1.选择标准化检测方法,提高检测精度。2.采集新鲜样品,缩短样品保存时间。3.关注重点指标,减少不必要的检测项目。4.加强产品的贮存管理,保证产品稳定性。5.与检测机构保持良好沟通,及时了解报告的有效期限。
调味品检测报告的应用主要体现在以下几个方面:1.指导生产管理,确保产品质量安全。2.为产品溯源提供依据,方便追查问题。3.满足监管部门的检查要求,保证企业合规经营。4.为产品出口创造有利条件,增强国际竞争力。5.为消费者提供产品信息,增强信任度。
综上所述,调味品检测报告的有效期是一个复杂的问题,需要综合考虑各种因素。只有充分掌握报告的有效期限,并采取有效措施延长其有效期,才能更好地发挥检测报告在食品安全中的作用。
欢迎来电咨询-15635143639